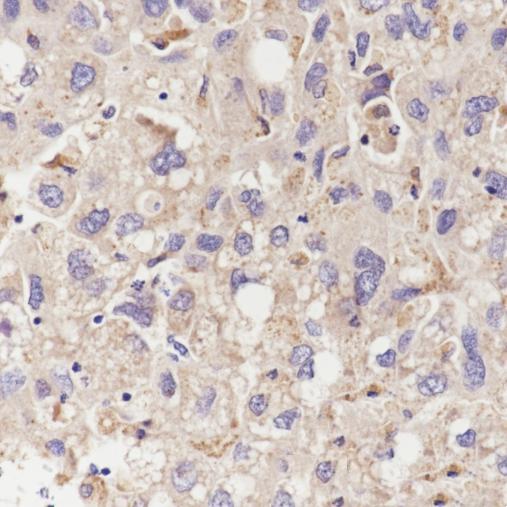

推荐应用
E3 ubiquitin-protein ligase synoviolin is an enzyme that in humans is encoded by the SYVN1 gene. This gene encodes a protein involved in endoplasmic reticulum (ER)-associated degradation. The encoded protein removes unfolded proteins, accumulated during ER stress, by retrograde transport to the cytosol from the ER. This protein also uses the ubiquitin-proteasome system for additional degradation of unfolded proteins. This gene and the mitochondrial ribosomal protein L49 gene use in their respective 3' UTRs some of the same genomic sequence. Sequence analysis identified two transcript variants that encode different isoforms.
推荐稀释比 WB:1/500-1/1000;IHC-P:1/50-1/100;ICC/IF:1/50

Western blot analysis of SYVN1 in lysates of A549,HeLa,HEK-293 and HepG2 using SYVN1 antibody.
Immunohistochemistry analysis of paraffin-embedded Human liver cancer using SYVN1 antibody.High pressure and temperature Tris/EDTA (PH 9.0) used for antigen retrieval.The brown color represents the positive signal observed with SYVN1 antibody.

Immunocytochemistry analysis of SYVN1(green) in HeLa cells using SYVN1 antibody,and DAPI(blue).
-25 ~ -15℃保存,收到货之后有效期1年,避免反复冻融。
【应用方向】抗体应用研究——肿瘤表观遗传学通路
11040
2026-04-14
【应用方向】抗体应用研究——心肌纤维化解析
20173
2026-04-14
【应用方向】抗体应用研究—心肌发育的分子解析与前沿转化
14858
2026-04-14
【应用方向】抗体应用研究——神经谱系标记物
9823
2026-04-14
【应用方向】抗体应用研究——基因转录表达调控(组蛋白修饰研究)
18681
2026-03-17
【应用方向】抗体应用研究——解锁动脉粥样硬化研究的核心密钥
7697
2026-03-17
【应用方向】抗体应用研究—细胞自噬与增殖
12694
2026-04-15
【应用方向】抗体应用研究—细胞死亡
20018
2026-04-14
【应用方向】经典信号通路-JAK/STAT信号转导通路及抗体推荐
13017
2026-04-14
【应用方向】经典信号通路-MAPK/ERK信号转导通路及抗体推荐
13762
2026-04-14
【应用方向】抗体应用研究--细胞器标记物
19195
2025-12-25
【应用方向】抗体应用研究—癌症疾病
17657
2026-04-15
【技术讲解】选对标签抗体,蛋白研究不用愁!
15783
2026-04-14





